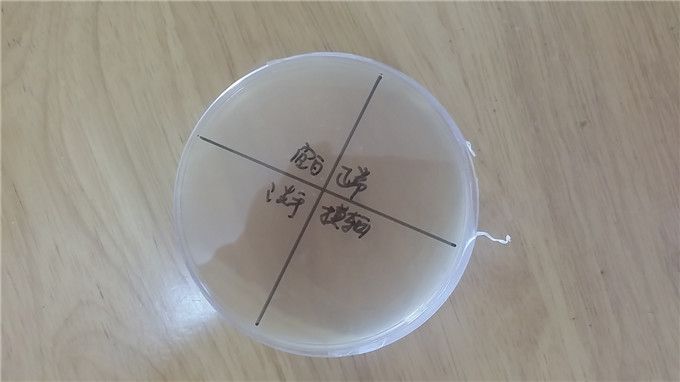
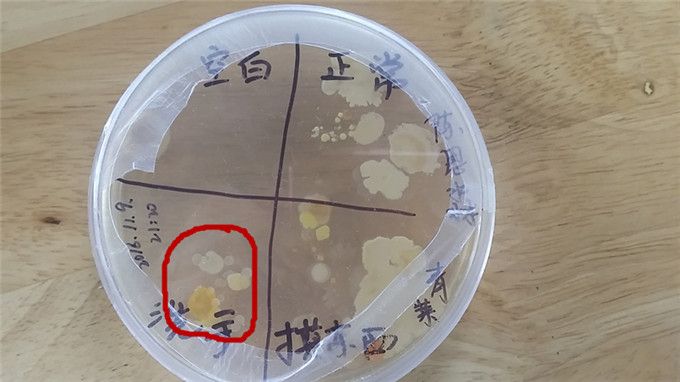
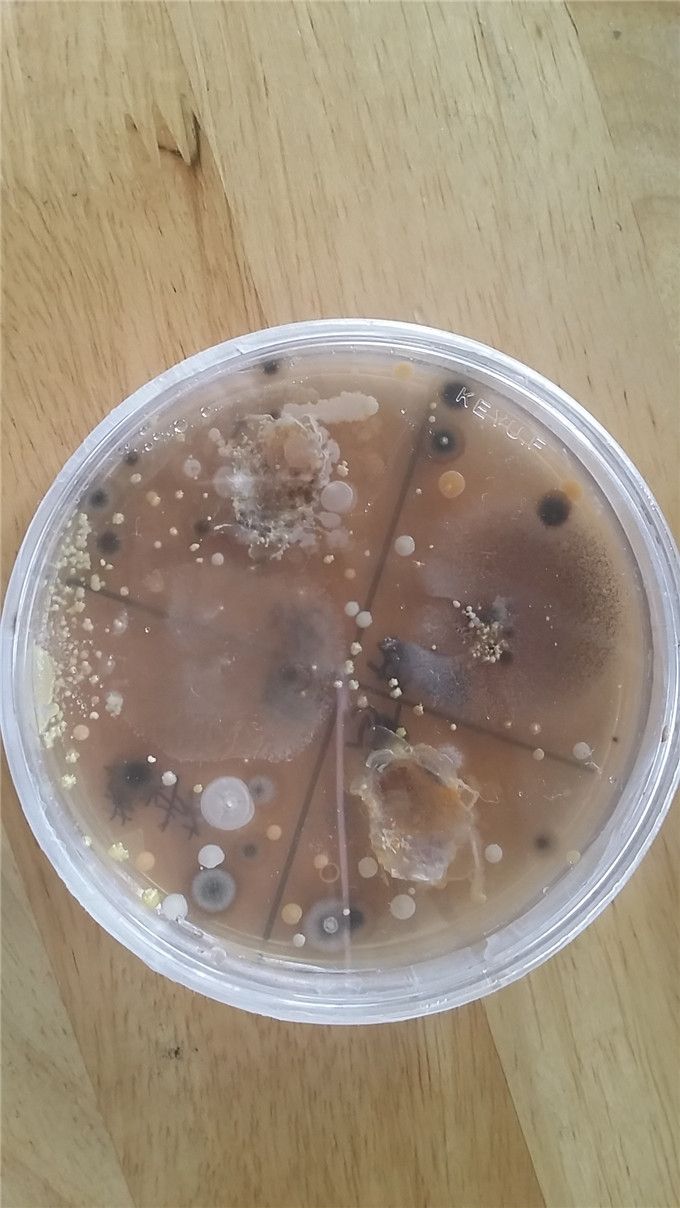

有害细菌很可怕,这类细菌为什么可怕?它又是怎么来的呢?孩子们在探究有关细菌的活动中,碰到了小难题啦!没关系,嘉恩妈妈给每个孩子准备了一个秘密武器,将带领孩子们一起探究关于细菌的小秘密!
原来呀,这个秘密武器叫“细菌培养皿”,嘉恩妈妈在上面先做上标记。瞧,标“正常”的区域为洗手前按的,标“洗手”的区域为洗手后按的,标“摸东西”的区域指蹭脏的地方按的,标“空白”的区域为对照区域不能碰。
孩子们将秘密武器带回家开始做实验啦!
“妈妈经常跟我说摸完钱要洗手,今天我要试一试钱上到底有多少细菌?”

“我想看看洗手池有没有细菌。”

“我先玩玩我家种的这盆台湾枸杞菜,再来实验,看看它过两天会不会长细菌?”

“玩过的玩具上有细菌吗?”“用过的牙刷上会有多少细菌?”


过了三、四天,哈哈……实验结果终于出来了!
孩子们纷纷带着各自做的实验结果来到班级交流分享。有的在课间与小伙伴交流,还有的到台前给同伴讲述自己的实验情况。






“钱真的很脏,你看这就是我摸了钱去按的地方,长出细菌了哎。”

“我玩过的玩具按的培养皿里有几只小虫子。”

看还有这么多可怕的细菌。



“咦? ……思淼洗过手去按的地方长出了细菌,诚敏洗过手去按的怎么没有长细菌呢?”“我知道,因为思淼手上还有细菌。”“一定是思淼的手洗得不够干净吧?”

“你看,细菌盒每天都有变化哦,里面的细菌一天比一天多!”妈妈帮找来了放大镜,还有显微镜比比看哪个工具看细菌能看得更清楚。


“嗯,对呀,我的盒子里都长满了细菌唉。”
为什么同一个细菌盒里会长出两种不一样的细菌?为什么同时做的实验,细菌长的速度不一样?……孩子们在种种的疑问与亲自实验的往返中观察、发现了其中的奥秘,亲自获悉了细菌与培养皿之间的许多秘密。有效地促进了他们的好奇心,激发了他们对科学实验的兴趣,同时也提高了孩子们在实验中积极思考与实践操作的能力。
(郑幼琼)